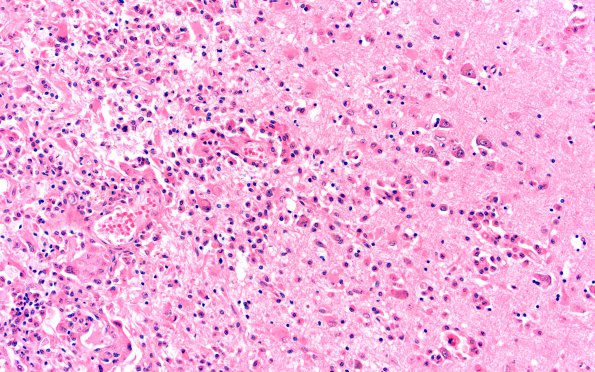
1B7 Metastases (Case 1) G H&E 20X 3

Table of Contents
Washington University Experience | NEOPLASMS (METASTASES) | Single Case | 1B7 Metastases (Case 1) G H&E 20X 3
In some areas there are neurons admixed with inflammatory cells and macrophages, a toxic soup enhancing neuronal irritability?